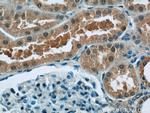
SREBF1 Antibody in Immunohistochemistry (Paraffin) (IHC (P))

Search
Proteintech
SREBF1 Polyclonal Antibody
{{$productOrderCtrl.translations['antibody.pdp.commerceCard.promotion.promotions']}}
{{$productOrderCtrl.translations['antibody.pdp.commerceCard.promotion.viewpromo']}}
{{$productOrderCtrl.translations['antibody.pdp.commerceCard.promotion.promocode']}}: {{promo.promoCode}} {{promo.promoTitle}} {{promo.promoDescription}}. {{$productOrderCtrl.translations['antibody.pdp.commerceCard.promotion.learnmore']}}
产品信息
14088-1-AP
种属反应
已发表种属
宿主/亚型
分类
类型
抗原
偶联物
形式
浓度
规格
纯化类型
保存液
内含物
保存条件
运输条件
产品详细信息
This antibody can recognize the 125 kDa precursor form and the 68 kDa mature form of human SREBF1.
Immunogen sequence: MDEPPFSEA ALEQALGEPC DLDAALLTDI EGEVGAGRGR ANGLDAPRAG ADRGAMDCTF EDMLQLINNQ DSDFPGLFDP PYAGSGAGGT DPASPDTSSP GSLSPPPATL SSSLEAFLSG PQAAPSPLSP PQPAPTPLKM YPSMPAFSPG PGIKEESVPL SILQTPTPQP LPGALLPQSF PAPAPPQFSS TPVLGYPSPP GGFSTGSPPG NTQQPLPGLP LASPPGVPPV SLHTQVQSVV PQQLLTVTAA PTAAPVTTTV TSQIQQVPVL LQPHFIKADS LLLTAMKTDG ATVKAAGLSP LVSGTTVQTG PLPTLVSGGT ILATVPLVVD AEK (1-332 aa encoded by BC063281)
靶标信息
Sterol regulatory element-binding proteins (SREBPs) are transcription factors that are members of the basic helix-loop-helix leucine zipper family of DNA binding proteins. Three isoforms have been identified in mammalian tissues that vary in structure, regulation, and function. SREBP-1a and SREBP-1c (originally cloned as ADD1) are protein products of alternative promoter usage of the SREBP-1 gene. The third isoform is transcribed from a different gene, SREBP-2. SREBPs are present as 120 kDa inactive precursors in the endoplasmic reticulum (ER) membrane. Upon activation, the SREBP protein is translocated to the Golgi and proteolytic cleavage occurs resulting in a mature transcriptionally active 60-78 kDa fragment. In liver and adipose tissues, SREBPs have a significant influence on lipid and cholesterol accumulation by inducing the transcription of genes involved in these processes. While SREBP-1 is thought to be more important in regulating the expression of genes involved in triglyceride synthesis and accumulation, SREBP-2 has been more closely linked to those involved in cholesterol synthesis and accumulation.
仅用于科研。不用于诊断过程。未经明确授权不得转售。
生物信息学
蛋白别名: bHLHd1; Class D basic helix-loop-helix protein 1; nt-SREBP1; SREBP-1; Sterol regulatory element-binding protein 1; Sterol regulatory element-binding transcription factor 1; unnamed protein product
基因别名: BHLHD1; HMD; IFAP2; SREBF1; SREBP1
UniProt ID: (Human) P36956
Entrez Gene ID: (Human) 6720